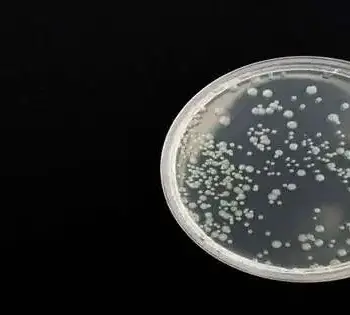

Bladder disease has one of the greatest occurrence rates on the planet and ranks as the fourth most normal growth in men. Notwithstanding its somewhat
Instruments smaller than a human hair are being intended to destroy infection-safe microscopic organisms and battle malignant growth. Dr. Ana Santos becomes profound while depicting what happened quite a while
According to a new study from the Universities of Surrey and Oxford, Loughborough University, and Radboud University in the Netherlands, electrical noise stimulation can aid in improving arithmetic learning in
A gathering of scientists reports that they have accomplished quantum intelligence at room temperature, which is the capacity of a quantum framework to keep a clear-cut state over the long
Princeton physicists have found an unexpected change in quantum conduct while exploring different avenues regarding a three-particle flimsy cover that can be effectively exchanged into a superconductor. The exploration vows